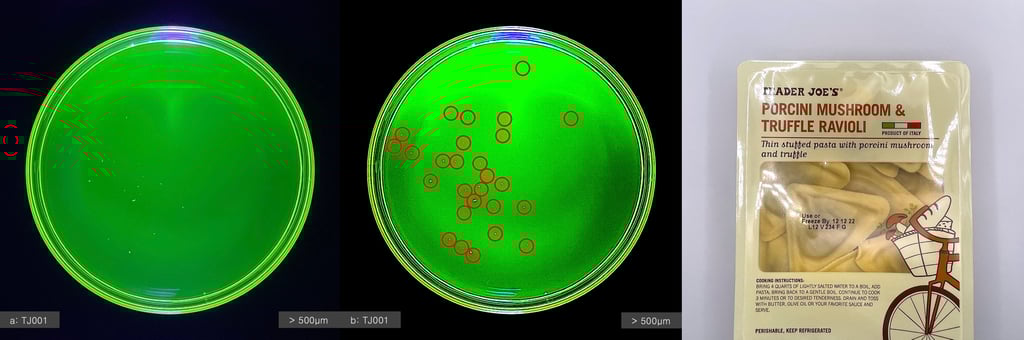
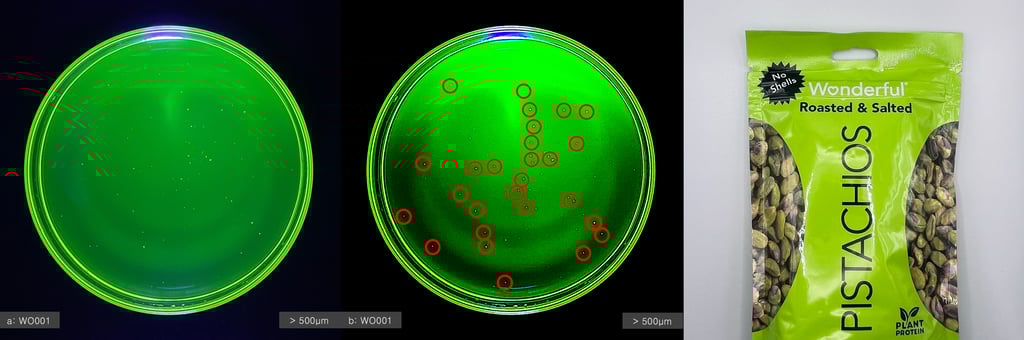

Findings
Recent observations into the transference of microplastics generated when opening food packaging.

Get in touch
Microplastics are ubiquitous in our environment, so minimizing involuntary plastic consumption is key for you and your family.
If you have questions about the Testing Kit, microplastics, or how to migrate to a plastic-free kitchen, drop us an note.
